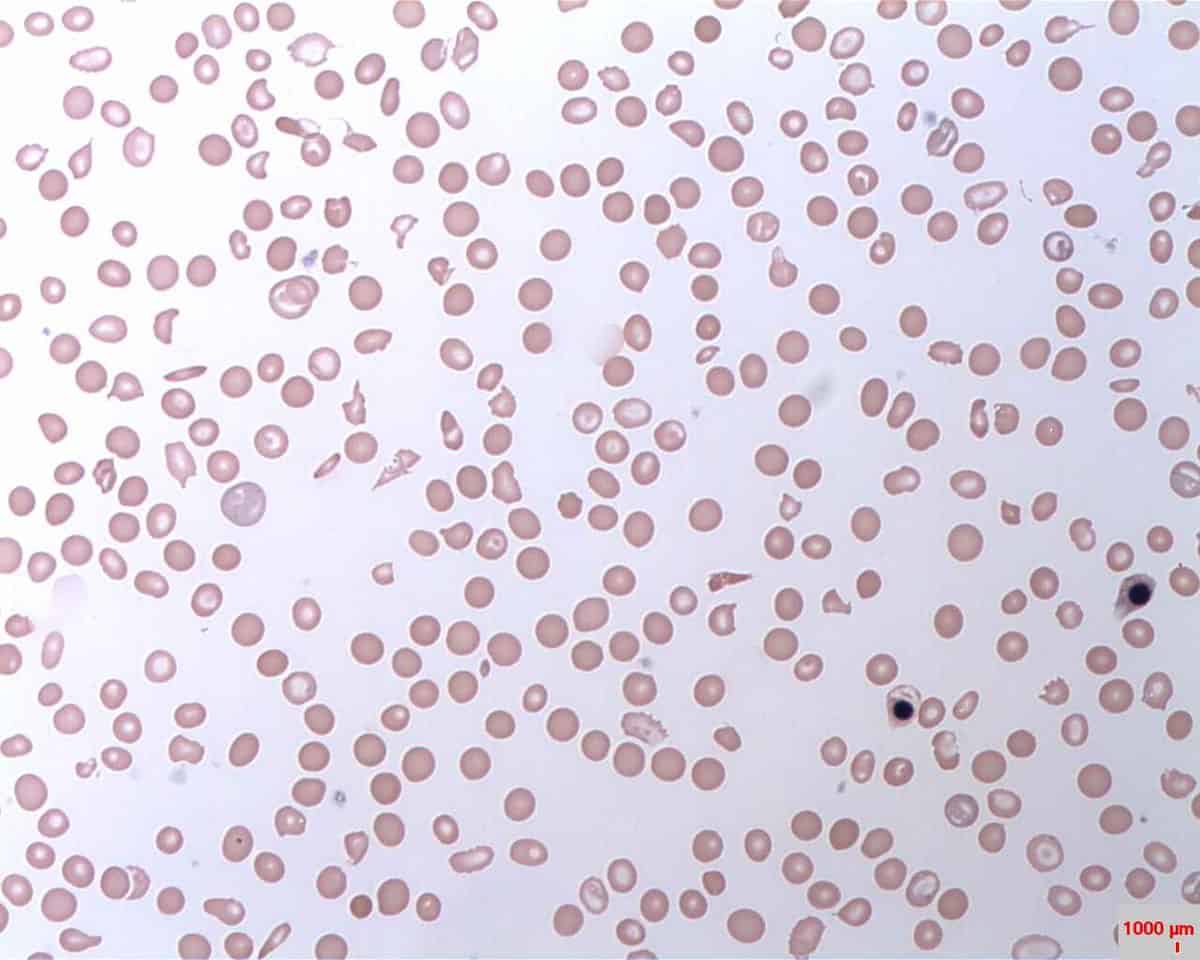
Paroxysmal nocturnal hemoglobinuria (PNH): पैरोक्सीमल नोकट्यूनल हिमोग्लोबिन्यूरिया (पीएनएच) क्या है?

परिचय-
यह एक दुर्लभ ब्लड रोग है जो आपके जीन (Gene) से उपजा है। यदि आपको पैरोक्सीमल नोकट्यूनल हिमोग्लोबिन्यूरिया (पीएनएच -Paroxysmal nocturnal hemoglobinuria) है, तो आपको प्रतिरक्षा प्रणाली शरीर में ब्लड सेल पर हमला करती हैं और उन्हें खत्म करती है, जिससे प्रोटीन की कमी होती है।
किसी भी उम्र में पैरोक्सीमल नोकट्यूनल हिमोग्लोबिन्यूरिया (पीएनएच – PNH) हो सकता हैं। हालांकि यह जानलेवा हो सकता है, इसका उपचार आपको बेहतर महसूस करने और इसकी कुछ जटिलताओं को नियंत्रित करने में मदद करता है।
और पढ़े: फाइबर का सेवन हर उम्र में है आवश्यक
PNH का प्राथमिक लक्षण मल मूत्र है। समय से पहले रेड ब्लड सेल को नष्ट करने से मूत्र में हीमोग्लोबिन निकलता है। हीमोग्लोबिन वह है जो आपके ब्लड को लाल बनाता है। आपके मूत्राशय में मूत्र जमा हो जाने के बाद रात में या सुबह में मलिनकिरण (discoloration) देख सकते हैं। हालांकि, PNH वाले कुछ लोग मलिनकिरण नहीं देख सकते हैं। हीमोग्लोबिन आपके मूत्र में उन स्तरों पर मौजूद हो सकता है जो केवल मूत्र को देखकर दिखाई नहीं देता हैं।
PNH (Paroxysmal nocturnal hemoglobinuria) होने के अन्य लक्षणों में शामिल हैं:
4-पेट में दर्द
5-आसानी से चोट
PNH (Paroxysmal nocturnal hemoglobinuria) की एक बहुत ही गंभीर जटिलता ब्लड क्लोट का गठन है। आपके प्लेटलेट्स ब्लड के क्लोट में शामिल हैं, और PNH आपके प्लेटलेट्स को घटा या बिगाड़ सकता है। PNH के लक्षण एक व्यक्ति से दूसरे व्यक्ति में व्यापक रूप से भिन्न हो सकता हैं। कुछ लोगों में केवल बहुत हल्के लक्षण होंगे, जबकि अन्य में गंभीर और जीवन-धमकाने वाली जटिलताओं का अनुभव हो सकता हैं।
PNH आनुवांशिक (Genetic) बीमारी है। लेकिन जरुरी नही कि आपके परिवार से ये बीमारी नही होती और न ही आने वाले बच्चें को होने दे सकते हैं। जीन में परिवर्तन, जिसे उत्परिवर्तन कहा जाता है, आपके शरीर को असामान्य रेड ब्लड सेल को बनाने का कारण बनता है। इन सेल में प्रोटीन नहीं होता है जो उन्हें आपकी प्रतिरक्षा प्रणाली (immune system) से अलग कर देता है। तो शरीर से खत्म होगा। वैज्ञानिक इस प्रक्रिया को “हेमोलिसिस’ (Hemolysis) कहते हैं।
कुछ डॉक्टरों का मानना है कि PNH कमजोर बोन मैरो (Bone marrow) से संबंधित है। एनीमिया वाले लोगों को एप्लास्टिक एनीमिया कहा जाता है जिसमें पीएनएच होने की अधिक संभावना होती है। इस स्थिति में, आपकी बोन मैरो (Bone marrow) नई ब्लड सेल को बनाना बंद कर देता है।
[mc4wp_form id=’183492″]
पीएनएच (PNH) का निदान करने के लिए डॉक्टर आपके लक्षणों पर विचार कर सकते हैं। मूत्र का मलिनकिरण, अस्पष्टीकृत ब्लड क्लोट, और एनीमिया (Anemia) प्रमुख सुराग हैं। ये बीमारी की पुष्टि करने के लिए अधिक परीक्षणों की आवश्यकता होती है।
ऐसे कई परीक्षण हैं जो रोग की पुष्टि करते हैं, लेकिन सबसे अच्छा परीक्षण रेड ब्लड सेल का एक प्रवाह साइटोमेट्री (Cytometry) विश्लेषण है। परीक्षण बहुत संवेदनशील है और रेड ब्लड सेल (Red blood cell) में प्रोटीन परत की अनुपस्थिति का पता लगा सकते हैं। परीक्षण के लिए, आपको ब्लड का एक छोटा सा नमूना देना होगा।

और पढ़ें– Blood Type Diet: ब्लड टाइप डायट क्या है?
पीएनएच (PNH) के लिए कोई ज्ञात जोखिम कारक नहीं हैं। इस स्थिति में PIGA नामक एक जीन शामिल है, लेकिन यह एक ऐसी बीमारी नहीं है जिसे आप अपने माता-पिता से विरासत में ले सकते हैं। यह रोग आनुवांशिक उत्परिवर्तन के माध्यम से प्राप्त होता है जो आपके पूरे जीवन में होता है। PNH तब होता है जब उत्परिवर्तन PIGA जीन के नुकसान की ओर जाता है।
पीएनएच तब होता है जब म्यूटेशन पीआईजीए जीन के नुकसान की ओर जाता है। उत्परिवर्तनों को “हेमटोपोइएटिक स्टेम सेल’ (Hematopoietic stem cells) कहा जाता है। ये आपके बोन मैरो में कोशिकाएं हैं जो ब्लड सेल के उत्पादन को जन्म देती हैं। यदि म्यूटेशन होता है, तो आप असामान्य ब्लड सेल का निर्माण करेंगे।
और पढ़ें– नहीं सुनपाने वाले लोगों के जीने की उम्मीद है साइन लैंग्वेज, जानें कब सिर्फ इशारे ही आते हैं काम
PIGA जीन की कमी से बीमारियों और जटिलताओं का सामना करना पड़ सकता है जो मामूली से लेकर जीवन के लिए खतरा हैं।
एनीमिया (Anemia) –
एनीमिया (Anemia) तब होता है जब रेड ब्लड सेल होता हैं, यह पीएनएच के साथ बहुत आम है जिसमें अलग-अलग तरह के कारण हो सकते हैं, लेकिन पीएनएच के मामले में, यह ब्लड सेल के समय से पहले नष्ट होने के कारण होता है। लक्षणों में शामिल हैं:
1-थकान
2-दुर्बलता
3-सिर दर्द
4-चक्कर
5-पीली त्वचा
तीव्र मायलोइड ल्यूकेमिया (Acute Myeloid Leukemia)
कम पीएनएच तीव्र मायलोइड ल्यूकेमिया का कारण बन सकता है। लक्षणों में शामिल हैं:
1-मसूड़ों से खून बहना
2-चोट
3-बुखार
4-सांसों की कमी
5-वजन घटना
6-त्वचा के चकत्ते
8-थकान
थ्रोमबोसिस (Thrombosis)
सबसे गंभीर जटिलता आम एनीमिया नहीं है, ब्लड क्लोट का गठन है। इस जटिलता को घनास्त्रता (thrombosis) के रूप में जाना जाता है। क्लोट के कारण शरीर में दर्द होता है। वे पूरे शरीर में भी घूम सकते हैं। लंग्स, मस्तिष्क या दिल के पास ब्लड क्लोट की वजह से स्ट्रोक और मृत्यु हो सकती है।
[mc4wp_form id=’183492″]
और पढ़ें– एपिसीओटॉमी की जटिलताएं क्या हैं?
पीएनएच के उपचार (PNH treatment) उसके लक्षणों पर निर्भर करता हैं। अधिकांश लोगों के लिए, लक्षणों का इलाज करना पीएनएच का सफलतापूर्वक प्रबंधन कर सकता है। एनीमिया का इलाज करने वाली दवाएं ब्लड सेल के टूटने को कम करती हैं और ब्लड क्लोट के बनने के जोखिम को कम करता हैं। रेड ब्लड सेल की गिनती बढ़ाने के लिए ब्लड आवश्यक हो सकता है।
आपको अपने इम्यून सिस्टम को दबाने के लिए स्टेरॉयड की जरुरत हो सकती है। आपका डॉक्टर संक्रमणों से सुरक्षित रखने के लिए टीकों की सिफारिश कर सकता है। अपने ब्लड सेल के स्तर को सामान्य रखने के लिए ब्लड संक्रमण की भी आवश्यकता हो सकती है।
कुछ रोगियों में एक दवाइयां (eculizumab) बहुत प्रभावी हो सकता हैं। यह रेड ब्लड सेल के टूटने को रोकता है और ब्लड आधान (transfusions) की आवश्यकता को प्रतिस्थापित करता है।
अपना ख्याल ऐसे रखें
जब आपको पीएनएच है तो अपना ख्याल रखना और भी अधिक महत्वपूर्ण होता है, इसलिए सर्वश्रेष्ठ महसूस करते हैं।
1- स्वस्थ आहार खाएं– विटामिन C से मिलने वाला आयरन आपको बेहतर तरीके से अवशोषित करता है। स्ट्रॉबेरी या संतरे के स्लाइस के साथ पालक सलाद जैसे विटामिन C के साथ लें।
2-व्यायाम करें– थकान के कारण एक्टिव रहना कठिन हो जाता है। अपने डॉक्टर से पूछें कि किस तरह की कसरत आपके लिए सबसे अच्छा है। यदि आप में रेड ब्लड सेल की संख्या बहुत कम है, तो उन गतिविधियों को छोड़ दें, जो आपके दिल की धड़कन को तेज कर सकती हैं क्योंकि इससे आपके छाती को चोट पहुंचाता हैं, या आपकी सांस को रोक सकती हैं।
3-अपनी केयर करें- कोशिश करें कि संक्रमण न हो अपने हाथ को अक्सर धोएं, और भीड़ और बीमार लोगों से बचें। अपने डॉक्टर को बताएं कि क्या आपको बुखार है या सामान्य से अधिक थकान महसूस होता है। पूछें कि क्या आप अपने टीकों पर अप-टू-डेट हैं?
4-सहायता प्राप्त करें- अन्य लोगों से बात करें जो जानते हैं कि आप क्या कर रहे हैं। अपने डॉक्टर से कनेक्ट होने के तरीकों के बारे में पूछें, जैसे कि पीएनएच सपोर्ट ग्रुप जो स्थानीय या ऑनलाइन मिलते हैं।
यदि आप एक महिला हैं जो गर्भवती होना चाहते हैं, तो पहले अपने डॉक्टर से बात करें। पीएनएच समस्या आपके और आपके बच्चे के लिए गर्भावस्था को जोखिम बना सकता है। यदि आप गर्भवती हो जाती हैं, तो आपके डॉक्टर आपको और बच्चे की बारीकी से देख-रेख करेंगे।
अपनी भावनाओं को बताएं- ये आपके स्वास्थ्य का भी हिस्सा हैं। अपने निदान के बाद क्रोध, उदासी या तनाव महसूस करना ठीक है। यह किसी के साथ भी बात करने में मदद करता है, खासकर अगर उन भावनाओं को आपके दैनिक जीवन में प्रभावित करना शुरू करता है। अपने डॉक्टर से सलाह जरुर लें।
आप सहायता समूह में शामिल होने पर भी विचार कर सकते हैं, जहां आप अन्य लोगों के साथ बात कर सकते हैं जो समझते हैं कि आप क्या कर रहे हैं क्योंकि वे वहाँ से जा रहे हैं। अपने डॉक्टर से भी इसके बारे में पूछें। आपके दोस्त और परिवार इसके बारे में बताएं ये आपके लिए मददगार होगा।
हैलो स्वास्थ्य किसी भी तरह की कोई भी मेडिकल सलाह नहीं दे रहा है, अधिक जानकारी के लिए आप डॉक्टर से संपर्क कर सकते हैं।
डिस्क्लेमर
हैलो हेल्थ ग्रुप हेल्थ सलाह, निदान और इलाज इत्यादि सेवाएं नहीं देता।
Paroxysmal nocturnal hemoglobinuria (PNH). https://www.hopkinsmedicine.org/kimmel_cancer_center/types_cancer/paroxysmal_nocturnal_hemoglobinuria_PNH.html. Accessed on /04/March/2020
Paroxysmal nocturnal hemoglobinuria. https://ghr.nlm.nih.gov/condition/paroxysmal-nocturnal-hemoglobinuria. Accessed on /04/March/2020
Paroxysmal nocturnal hemoglobinuria (PNH). https://medlineplus.gov/ency/article/000534.htm. Accessed on /04/March/2020
What You Need to Know About Paroxysmal Nocturnal Hemoglobinuria. https://www.healthline.com/health/paroxysmal-nocturnal-hemoglobinuria-pnh. Accessed on /04/March/2020
Paroxysmal nocturnal hemoglobinuria https://www.hopkinsmedicine.org/kimmel_cancer_center/types_cancer/paroxysmal_nocturnal_hemoglobinuria_PNH.html Accessed on /04/March/2020
Paroxysmal Nocturnal Hemoglobinuria. https://rarediseases.org/rare-diseases/paroxysmal-nocturnal-hemoglobinuria/. Accessed on /04/March/2020
Current Version
03/05/2021
Poonam द्वारा लिखित
के द्वारा मेडिकली रिव्यूड डॉ. प्रणाली पाटील
Updated by: Toshini Rathod